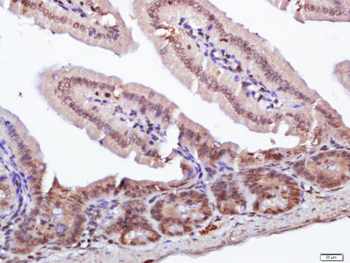
产品细节图片4
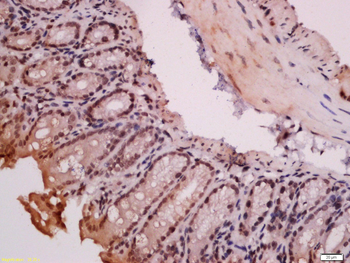
产品细节图片8

产品描述:RORC Rabbit Polyclonal Antibody
别名:RORG_HUMAN; Nuclear receptor ROR-gamma; ROR gamma; NR1F3; RZRG; TOR; IMD42; RZR-GAMMA; Nuclear receptor RZR-gamma; Nuclear receptor subfamily 1 group F member 3; RAR-related orphan receptor C; Retinoid-related orphan receptor-gamma; ROR gamma T [Mus musculus]; nuclear receptor ROR-gamma isoform 2; RORgT;
免疫原:KLH conjugated synthetic peptide derived from human ROR Gamma (81-140/518aa)
预测反应性:Bovine, Canine, Equine, Gallus, Porcine, Rabbit
分子量:57 kDa
应用稀释比例:WB=1:500-2000, IHC-P=1:100-500, IHC-F=1:100-500, ICC/IF=1:100-500, IF=1:100-500, Flow-Cyt=1ug/test
防腐剂:0.01M TBS (pH7.4) with 1% rAlbumin, 0.02% Proclin300 and 50% Glycerol.
纯化:Affinity purified by Protein A
保存说明:Maintain refrigerated at 2-8°C for up to 2 weeks. For long term storage store at -20°C in small aliquots to prevent freeze-thaw cycles.
Pubmed:27035541, 33011826
UniProt ID:P51449
Note:For research use only.
Blank control (black line): HepG2. Primary Antibody (green line): Rabbit Anti-ROR Gamma antibody (orb6888), dilution: 1 ug/Test, Secondary Antibody (white blue line): Goat anti-rabbit IgG-AF488, dilution: 0.5 ug/Test. Isotype control (orange line): Normal Rabbit IgG, Protocol, The cells were fixed with 4% PFA (10 min at room temperature) and then permeabilized with 90% ice-cold methanol for 20 min at -20°C, The cells were then incubated in 5% BSA to block non-specific protein-protein interactions for 30 min at room temperature. Cells stained with Primary Antibody for 30 min at room temperature. The secondary antibody used for 40 min at room temperature. Acquisition of 20000 events was performed.

Blank control: Molt-4. Primary Antibody (green line): Rabbit Anti-ROR Gamma antibody (orb6888), dilution: 1 µg/10^6 cells, Isotype Control Antibody (orange line): Rabbit IgG. Secondary Antibody: Goat anti-rabbit IgG-AF647, dilution: 1 µg/Test. Protocol The cells were fixed with 4% PFA (10 min at room temperature) and then permeabilized with 90% ice-cold methanol for 20 min at -20°C. The cells were then incubated in 5% BSA to block non-specific protein-protein interactions for 30 min at at room temperature. Cells stained with Primary Antibody for 30 min at room temperature. The secondary antibody used for 40 min at room temperature. Acquisition of 20000 events was performed.

HepG2 cell, 4% Fixative-fixed, Triton X-100 at room temperature for 20 min, Blocking buffer (normal goat serum) at 37°C for 20 min, Antibody incubation with (ROR Gamma) polyclonal Antibody, Unconjugated (orb6888) 1:100, 90 minutes at 37°C, followed by a conjugated Goat Anti-Rabbit IgG antibody at 37°C for 90 minutes, DAPI (blue) was used to stain the cell nuclei.
Fixative-fixed, paraffin embedded (mouse intestines), Antigen retrieval by boiling in sodium citrate buffer (pH6.0) for 15 min, Block endogenous peroxidase by 3% hydrogen peroxide for 20 minutes, Blocking buffer (normal goat serum) at 37°C for 30 min, Antibody incubation with (Gamma) Polyclonal Antibody, Unconjugated (orb6888) at 1:400 overnight at 4°C, followed by a conjugated secondary for 20 minutes and DAB staining.
Sample: Lane 1: Mouse Muscle Lysates, Lane 2: Rat Muscle Lysates, Primary: Anti-ROR Gamma (orb6888) at 1/1000 dilution, Secondary: IRDye800CW Goat Anti-Rabbit IgG at 1/20000 dilution, Predicted band size: 57 kD, Observed band size: 50 kD.
Sample: Liver (Mouse) Lysate at 40 ug, Primary: Anti-ROR Gamma (orb6888) at 1/1000 dilution, Secondary: IRDye800CW Goat Anti-Rabbit IgG at 1/20000 dilution, Predicted band size: 57 kD, Observed band size: 50 kD.
Sample: Liver (Mouse) Lysate at 40 ug, Primary: Anti-ROR Gamma (orb6888) at 1/300 dilution, Secondary: HRP conjugated Goat-Anti-rabbit IgG (orb572747) at 1/5000 dilution, Predicted band size: 57 kD, Observed band size: 57 kD.
Tissue/Cell: mouse colon tissue, 4% Fixative-fixed and paraffin-embedded, Antigen retrieval: citrate buffer (0.01M, pH6.0), Boiling bathing for 15 min, Block endogenous peroxidase by 3% Hydrogen peroxide for 30 min, Blocking buffer (normal goat serum) at 37°C for 20 min, Incubation: Anti-ROR Gamma Polyclonal Antibody, Unconjugated (orb6888) 1:200, overnight at 4°C, followed by conjugation to the secondary antibody and DAB staining.
Tissue/Cell: mouse colon tissue, 4% Fixative-fixed and paraffin-embedded, Antigen retrieval: citrate buffer (0.01M, pH6.0), Boiling bathing for 15 min, Block endogenous peroxidase by 3% Hydrogen peroxide for 30 min, Blocking buffer (normal goat serum) at 37°C for 20 min, Incubation: Anti-ROR Gamma Polyclonal Antibody, Unconjugated (orb6888) 1:200, overnight at 4°C, followed by conjugation to the secondary antibody and DAB staining.

文献和实验
文献和实验 技术资料
技术资料









